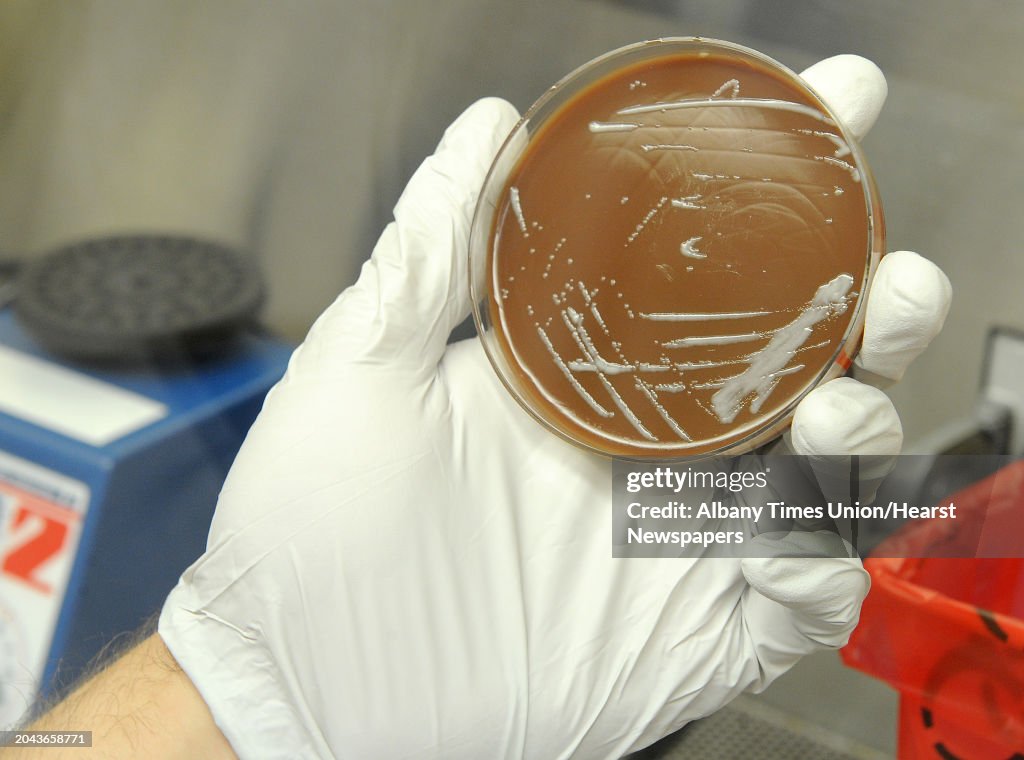
Albany Times Union

Albany Times Union
PhD. student Brian Franz holds Francisella Tularensis bacteria growth on a chocolate agar plate under a hood in a lab where research is done on vaccines at Albany Medical College on Monday, Sept. 9, 2013 in Albany, N.Y. (Photo by Lori Van Buren/Albany Times Union via Getty Images)

ACQUISTA UNA LICENZA
Come posso utilizzare questa immagine?
385,00 €
EUR
Getty ImagesAlbany Times Union, Foto di attualità Albany Times Union Scarica foto di attualità Premium ad elevata risoluzione da Getty ImagesProduct #:2043658771
Albany Times Union Scarica foto di attualità Premium ad elevata risoluzione da Getty ImagesProduct #:2043658771
Albany Times Union Scarica foto di attualità Premium ad elevata risoluzione da Getty ImagesProduct #:2043658771
Albany Times Union Scarica foto di attualità Premium ad elevata risoluzione da Getty ImagesProduct #:2043658771475€175€
Getty Images
In stockDETTAGLI
Restrizioni:
Contatta l'ufficio locale per informazioni su qualsiasi tipo di uso commerciale o promozionale.
Attestazione:
N. Editorial:
2043658771
Collezione:
Hearst Newspapers
Data di creazione:
9 settembre 2013
Data di upload:
Tipo di licenza:
Info sulla liberatoria:
Senza liberatoria. Ulteriori informazioni
Fonte:
Hearst Newspapers
Nome oggetto:
0910_vaccines
Max. dimensione file:
4000 x 2970 px (33,87 x 25,15 cm) - 300 dpi - 4 MB